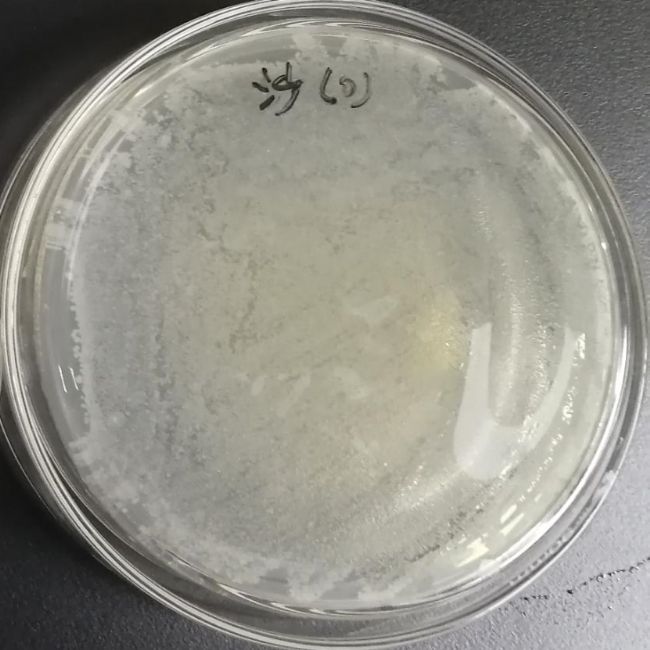
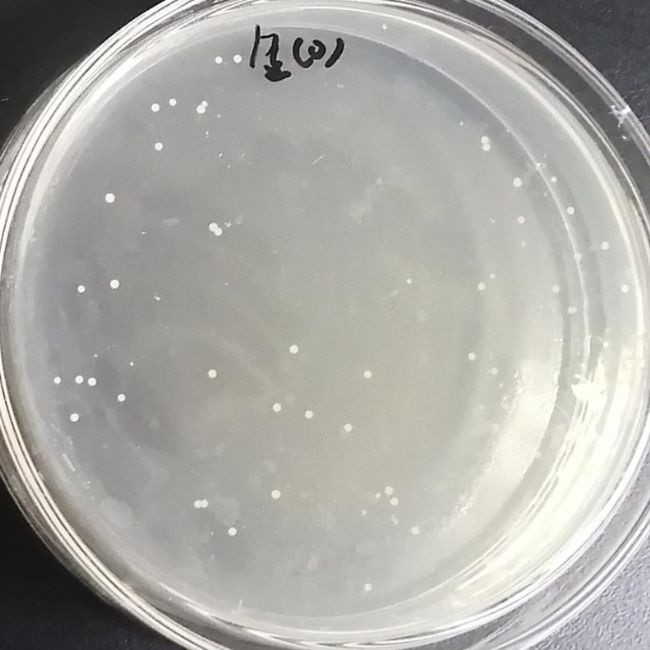

培養(yǎng)基內成分可以在運送過程中保護標本、維持標本生存,能保持氧化還原較低的電勢及穩(wěn)定的pH值。
后續(xù)的應用可用于厭氧菌、需氧菌和苛養(yǎng)菌的細菌培養(yǎng)及細菌和衣原體的抗原及核酸檢測。
·產品特點

1.無抑制物,可應用于抗原和核酸檢測
2.原材料經過嚴格篩選,性能有保障
3.批間差異小,穩(wěn)定性高
·實驗結果
使用逗邦®Amies運送培養(yǎng)基培養(yǎng)鼠傷寒沙門菌、金黃色葡萄球菌,生長情況見下圖,培養(yǎng)效果好。

訂購信息
